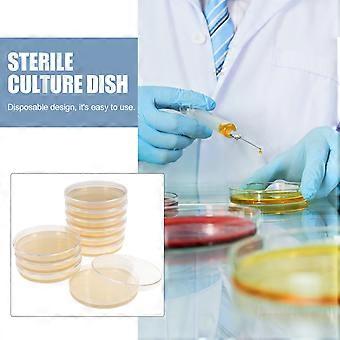

10 قطع لوحات أجار المحمولة مسبقة السكب أطباق أجار بتري معرض العلوم اللوازم
والشحن مجاناً
10 قطع لوحات أجار المحمولة مسبقة السكب أطباق أجار بتري معرض العلوم اللوازم
- العلامة التجارية: Unbranded

10 قطع لوحات أجار المحمولة مسبقة السكب أطباق أجار بتري معرض العلوم اللوازم
- العلامة التجارية: Unbranded
| سعر البيع القطاعي المقترح: | |
| السعر: | |
| أنت توفر: | ٢٬٦٥٠٫٠٠ E£ (69%) |
في المخزون
نقبل وسائل الدفع الآتية
الوصف
- العلامة التجارية: Unbranded
- الفئة: أطباق بتري
-
الحجم: 9.00 × 9.00 × 1.00 سم
- هوية Fruugo: 324571289-719159985
- EAN: 4362967321281
معلومات سلامة المنتج
يرجى الاطلاع على معلومات سلامة المنتج الخاصة بهذا المنتج الموضحة أدناه
يتم توفير المعلومات التالية من قبل بائع التجزئة المستقل التابع لجهة خارجية الذي يبيع هذا المنتج.
ملصقات سلامة المنتج

التسليم والرد
يُرسل خلال ٢ أيام
-
STANDARD: مجاناً - التسليم بين الثلاثاء 28 أكتوبر 2025 – الثلاثاء 04 نوفمبر 2025 - مجاناً
يُشحن من الصين.
نحن نبذل قصارى جهدنا لضمان أن تصلك المنتجات التي تطلبها بالكامل وطبقاً المواصفات التي حددتها. إلا أنه في حال تلقيك طلب غير كامل أو أغراض تختلف عن تلك التي طلبتها أو كان هناك سبب آخر يدعوك لعدم الرضاء عن الطلب، فيمكنك رد الطلب أو أي منتجات يتضمنها الطلب واسترداد ما دفعته من أجل تلك الأغراض بالكامل. عرض سياسة الرد الكاملة
تفاصيل امتثال المنت
يرجى الاطلاع على معلومات الامتثال الخاصة بهذا المنتج الموضحة أدناه.
يتم توفير المعلومات التالية من قبل بائع التجزئة المستقل التابع لجهة خارجية الذي يبيع هذا المنتج.
الجهة المصنعة:
توضح المعلومات التالية تفاصيل الاتصال الخاصة بالجهة المصنعة للمنتج ذي الصلة والذي يُباع على Fruugo.
- Shenzhen Juyuan Xunnuo Technology Co., Ltd.
- Shenzhen Juyuan Xunnuo Technology Co., Ltd.
- Room 201, 2nd Floor, Building D, Bailian Qimengcheng, No. 11 Shuitian 1st Road, Baolong Street, Longgang District, Shenzhen
- Shenzhen
- CN
- 518000
- odoresque@163.com
- 18188607148
الشخص المسؤول في الاتحاد الأوروبي:
توضح المعلومات التالية معلومات الاتصال الخاصة بالشخص المسؤول في الاتحاد الأوروبي. الشخص المسؤول هو المُشغل الاقتصادي المُعيّن والكائن في الاتحاد الأوروبي والمسؤول عن التزامات الامتثال المتعلقة بالمنتج ذي الصلة الذي يُباع داخل الاتحاد الأوروبي.
- MARWAY Consulting UG (haftungsbeschrankt)
- MARWAY Consulting UG (haftungsbeschrankt)
- Am Maibusch 108 -110,45883, Gelsenkirchen, Germany
- Gelsenkirchen
- DE
- 45833
- MARWAY.UG@outlook.com
- 4917645084650